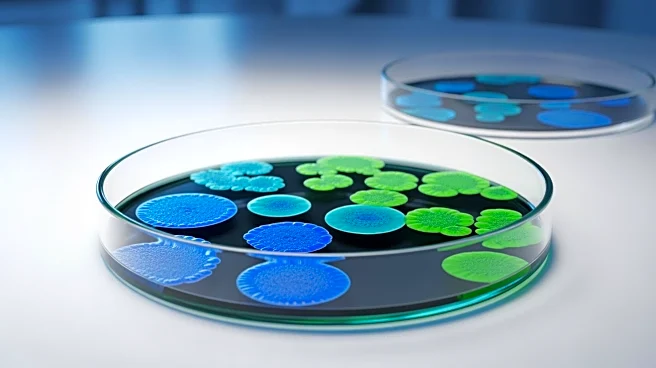
ImpetusDX Launches IDX Oral Health Microbial Testing Panel for Enhanced Periodontal Care

What's Happening?
A recent study highlights the effectiveness of teledentistry in promoting oral health among young children, particularly in preventing early childhood caries (ECC). The initiative, guided by the Bangkok Declaration and the Developmental Origins of Health
and Disease (DOHaD) concept, involved 64 parents of children aged 0-5 years. These parents participated in teleconsultations conducted by 118 supervised undergraduate students. The students collected data on caries risk and provided educational support to parents. The study found that 86% of the parents participated in at least two teleconsultations, with significant improvements in oral health habits. Notable changes included increased use of fluoride toothpaste, higher brushing frequency, and reduced sugar consumption. The study also noted that children with employed and more educated mothers showed more positive habit changes.
Why It's Important?
The study underscores the potential of teledentistry as a tool for improving oral health in young children, which is crucial for preventing ECC and other chronic non-communicable diseases. By leveraging technology, teledentistry can provide accessible and effective oral health education, particularly for families who may face barriers to traditional dental care. This approach not only promotes healthier habits but also reduces the risk of dental issues that can have long-term health implications. The findings suggest that teledentistry could be a valuable component of public health strategies aimed at improving pediatric oral health outcomes, especially in underserved communities.
What's Next?
The success of this teledentistry initiative may encourage further integration of digital health solutions in pediatric dentistry. Future steps could involve expanding the program to reach more families and exploring partnerships with educational institutions to train more students in delivering teleconsultations. Additionally, policymakers might consider supporting similar initiatives through funding and resources to enhance public health efforts. Continued research could also focus on long-term outcomes of teledentistry interventions and their impact on reducing healthcare costs associated with dental diseases.
Beyond the Headlines
The use of teledentistry raises important considerations regarding access to technology and digital literacy among parents. Ensuring that all families can benefit from such programs may require addressing disparities in technology access and providing support for those less familiar with digital tools. Furthermore, the ethical implications of data privacy and security in telehealth services must be carefully managed to protect patient information. As teledentistry becomes more prevalent, it could also influence cultural perceptions of dental care, shifting towards more proactive and preventive approaches.